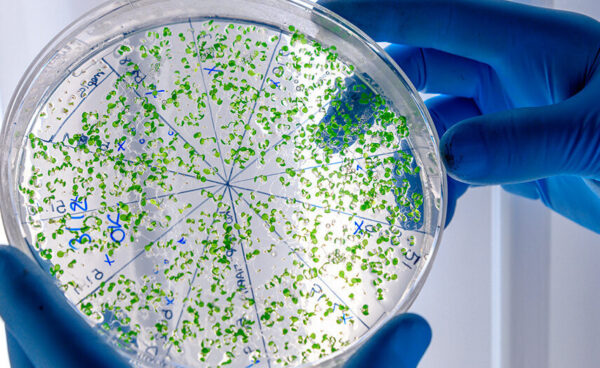

Um homem de 50 anos está internado com diagnóstico confirmado de meningite meningocócica em Sergipe. A informação foi divulgada nesta quarta-feira (11) pela Secretaria de Estado da Saúde (SES), que acompanha o caso por meio das equipes de vigilância epidemiológica.
De acordo com a pasta, o paciente realizou exames em uma unidade da rede estadual de saúde e, atualmente, permanece internado no Hospital e Maternidade Santa Isabel, localizado em Aracaju. O homem é residente do interior da Bahia e segue recebendo acompanhamento nas áreas da medicina e da enfermagem.
Segundo a Secretaria de Estado da Saúde, o quadro clínico apresenta evolução considerada favorável. A equipe médica mantém o tratamento conforme os protocolos estabelecidos para a doença, enquanto as autoridades de saúde monitoram a situação.
Como medida preventiva, a SES informou que pessoas que tiveram contato próximo com o paciente estão sendo acompanhadas pelas equipes de vigilância. O objetivo é evitar a possível propagação da infecção e garantir resposta rápida caso surjam novos sintomas entre os contatos.
A meningite meningocócica é causada pela bactéria Neisseria meningitidis e provoca inflamação nas membranas que envolvem o cérebro e a medula espinhal. A doença pode evoluir rapidamente e exige diagnóstico e tratamento imediatos.
Entre os sintomas mais comuns estão febre alta, dor de cabeça intensa, rigidez na nuca, náuseas, vômitos e, em alguns casos, manchas arroxeadas na pele. A transmissão ocorre por meio de secreções respiratórias, como as liberadas ao tossir, espirrar ou em contato próximo, como beijo.
A Secretaria de Estado da Saúde de Sergipe reforça que a vacinação é a principal forma de prevenção contra a meningite. As doses estão disponíveis gratuitamente nas Unidades Básicas de Saúde dos municípios sergipanos.
A pasta também informou que o cenário epidemiológico no estado segue sob monitoramento permanente, com vigilância ativa para identificação de novos casos e adoção de medidas de controle quando necessário.
Por Redação
Foto: Freepik

Comente